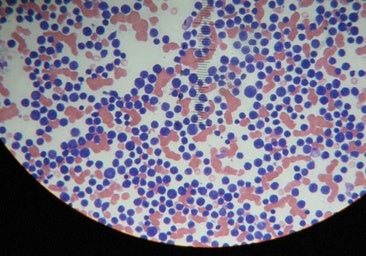
Una innovadora terapia CAR-T española rescata a pacientes con linfoma

CÁNCER
Llega la terapia CAR-T 'acorazada' para los linfomas más resistentes
La nueva versión, modificada para secretar interleucina 18 (IL18), una citocina proinflamatoria capaz de fortalecer el sistema inmunitario, recluta nuevas células inmunitarias para apoyar a las células T modificadas
Carl June: «He visto vivir a enfermos de cáncer que ya se habían pagado su funeral»


Esta funcionalidad es sólo para registrados
Iniciar sesiónEn la década de los años 80 el equipo de Carl June de la Universidad de Pensilvania (EE.UU.) fue pionero en el campo de la inmunoterapia, en concreto por el desarrollo de la terapia con células T contra el cáncer (CAR-T), tratamiento ... que revolucionó el manejo de algunos tipos de cáncer de la sangre.
Sin embargo, algunas CAR-T ya comercializadas no consiguen su objetivo en algunos tipos de leucemia. Ahora, el equipo de June ha diseñado una nueva terapia de células T CAR «acorazadas» de última generación que, en un pequeño estudio con pacientes cuyos linfomas de células B seguían resistiendo múltiples rondas de otros tratamientos contra el cáncer, logro reducir el cáncer en el 81 % de los pacientes y logró una remisión completa en el 52 %.
Los hallazgos, dirigidos por investigadores de la Facultad de Medicina Perelman de la Universidad de Pensilvania, se publican en el 'New England Journal of Medicine'.
Una innovadora terapia CAR-T española rescata a pacientes con linfoma
R. IbarraUn 60 % de los pacientes en remisión completa seguían libres de recaída tras un seguimiento medio de 34 meses
Ms del 50 % de los pacientes con linfoma que reciben la terapia con células CAR-T disponible actualmente no experimentan una remisión a largo plazo. Para aquellos cuyos cánceres regresan o se vuelven resistentes después de la terapia con células CAR-T, el pronóstico es, lamentablemente, malo, con pocas opciones restantes.
La terapia CAR-T comercial se ha consolidado en los últimos años como un tratamiento habitual para pacientes con distintos tipos de linfoma, señala a ABC Salud Julio Delgado, jefe de la Unidad de Oncoinmunoterapia del Hospital Clínic de Barcelona. En nuestro país, dice, «disponemos de productos comerciales para el linfoma difuso de células grandes, el linfoma folicular y el linfoma de células del manto. Sin embargo, esta terapia no es infalible, y existe un grupo de pacientes que se quedan sin opciones cuando fracasan tras recibir CAR-T».
Este estudio, añade el también portavoz de la Sociedad Española de Hematología y Hemoterapia (SEHH) aporta una posible solución para estos pacientes que ya han sido tratados con CAR-T convencional sin éxito.
Flexibilidad
Explica Delgado que «una de las ventajas más fascinantes de la terapia CAR-T es su flexibilidad: una vez modificados los linfocitos T para identificar un antígeno, pueden añadirse otras modificaciones».
En este caso, «se ha logrado que los linfocitos T, además de reconocer las células malignas por la proteína CD19 en su superficie, secreten una citocina específica, la interleucina 18. Esta interleucina mejora la capacidad de las células CAR-T para eliminar las células tumorales. Es decir, en el entorno local del tumor se liberan estas citocinas, cuya función natural es precisamente ayudar al sistema inmune a destruir las células cancerosas».
Este truco molecular, como señala Ignacio Melero, catedrático de Inmunología de la Universidad de Navarra, «consiste en introducir en los linfocitos, junto con del gen CAR, otro gen que codifica para una sustancia inmunoestimulante denominada interleuquina-18. Los CAR-T así construidos para coexpresar citoquinas se denominan CAR-T acorazados, y tienen mayor potencia terapéutica. Este concepto se ha probado preclínica y clínicamente con otras citoquinas, pero con resultados clínicos más modestos».
Detalla Jakub Svoboda, quien dirigió el ensayo clínico en el Centro Oncológico Abramson de Penn Medicine, que esta versión, modificada para secretar interleucina 18 (IL18), una citocina proinflamatoria capaz de fortalecer el sistema inmunitario, recluta nuevas células inmunitarias para apoyar a las células T modificadas. De esta manera, «protege aún más a las células CAR-T y promueve su capacidad para atacar a las células cancerosas», explica June.
Ensayo clínico
Los 21 pacientes de este ensayo clínico de fase I habían recibido una mediana de siete terapias adicionales antes de inscribirse en el estudio, y todos, excepto uno, ya habían probado una terapia con células CAR-T aprobada para su tipo de cáncer. Cuando el cáncer continúa avanzando a pesar de tratamientos agresivos como este, se debe en parte a la inmunosupresión y al agotamiento de las células T, que reducen la eficacia de las terapias contra el cáncer.
Este estudio representa un avance significativo en la evolución de la terapia con células CAR T, ya que es la primera vez que se prueba una terapia CAR T potenciada con citocinas en pacientes con cáncer de sangre. Al analizar muestras de sangre de pacientes tras recibir el tratamiento, el equipo halló evidencia sólida que indica que la adición de IL18 a las células CAR T contribuyó a las altas tasas de respuesta.
Esta estrategia podría ser eficaz en entornos donde las células CAR-T no han tenido el mismo rendimiento, como en los tumores sólidos
«Creemos que la incorporación de la secreción de citocinas en el diseño de células CAR-T tendrá amplias implicaciones para mejorar las terapias celulares, incluso más allá de los cánceres hematológicos -afirma June-. Con una mayor persistencia y expansión de las células T, esta estrategia podría ser eficaz en entornos donde las células CAR-T no han tenido el mismo rendimiento, como en los tumores sólidos».
«Hasta donde yo sé -comenta Delgado-, este tipo de CAR-T «acorazados», es decir, reforzados mediante la secreción de citocinas, no se están utilizando actualmente en España, ni siquiera en ensayos clínicos».
Lo que sí se está explorando en nuestro país, añade, son CAR-T con doble o triple especificidad. Por ejemplo, «en pacientes que han fracasado con CAR-T anti-CD19, se están probando productos con doble especificidad (anti-CD19 y anti-CD20, anti-CD19 y anti-CD22, anti-CD19 y BCMA, etc.), con varios ensayos en marcha para evaluar si esta estrategia puede revertir los fracasos previos».
La producción de huCART19-IL18 también utiliza un proceso, desarrollado por el Centro de Inmunoterapias Celulares de Penn, que acorta el tiempo de fabricación de las células CAR-T a tan solo tres días. Para pacientes con cánceres agresivos y de rápido crecimiento, esto significa poder iniciar la terapia con células CAR-T más rápidamente que con los tiempos de fabricación estándar actuales de nueve a catorce días. Investigaciones previas han sugerido que este menor tiempo de fabricación también podría mejorar la potencia de las células T.
El equipo de June ya tiene previstos varios ensayos clínicos adicionales, incluyendo estudios que ampliarán el huCART19-IL18 a pacientes con leucemia linfocítica aguda (LLA) y leucemia linfocítica crónica (LLC). Otro ensayo para linfoma no Hodgkin, que utiliza un producto similar de células T CAR con blindaje de IL18, está actualmente reclutando pacientes,
«Estamos expectantes ante la llegada de estos nuevos productos, ya sea en el contexto de ensayos clínicos o, eventualmente, aprobados y disponibles para su uso generalizado», concluye Delgado,
Límite de sesiones alcanzadas
- El acceso al contenido Premium está abierto por cortesía del establecimiento donde te encuentras, pero ahora mismo hay demasiados usuarios conectados a la vez. Por favor, inténtalo pasados unos minutos.
Has superado el límite de sesiones
- Sólo puedes tener tres sesiones iniciadas a la vez. Hemos cerrado la sesión más antigua para que sigas navegando sin límites en el resto.
Esta funcionalidad es sólo para suscriptores
Suscribete
Esta funcionalidad es sólo para registrados
Iniciar sesiónEsta funcionalidad es sólo para suscriptores
Suscribete